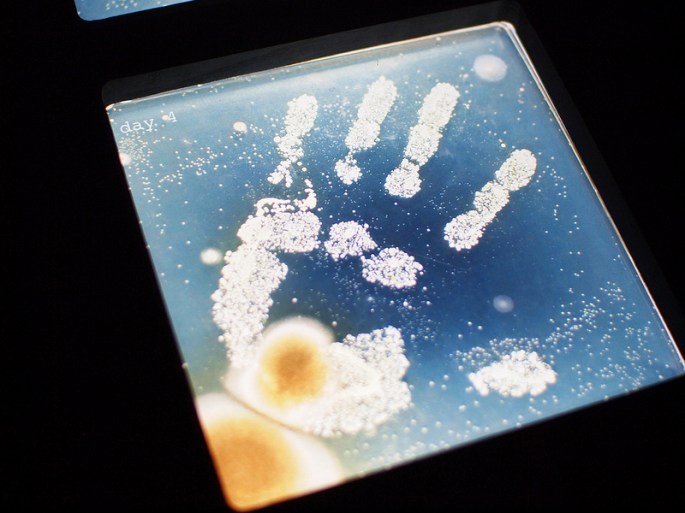

Welcome to 2017 and a whole new year of biodefense news! While you’re heading back to work, make sure to wash your hands and stay safe – the CDC has reported increasing flu activity.
The Best of Bio and Chem Weapons Coverage in 2016
The Bulletin of the Atomic Scientists has put together their “five best articles” for bio-chem weapons in 2016 and we were happy to see two familiar faces – GMU PhD alum Daniel M. Gerstein and GMU Biodefense professor, Sonia Ben Ouagrham-Gormley. Daniel Gerstein’s article, How genetic editing became a national security threat, discusses the threatening components of gene drive, like low cost and growing availability. “Armed with the proper genetic sequences, states or bioterrorists could employ genome editing to create highly virulent pathogens for use in such attacks. They could, for example, change a less dangerous, non-pathogenic strain of anthrax into a highly virulent form by altering the genome, or recreate pathogens such as the deadly smallpox virus, which was eradicated in the wild in 1980.” Sonia Ben Ouagrham-Gormley teamed up with Kathleen Vogel to discuss the good, bad, and the hype of gene drive. They emphasize the importance of understanding gene drive to really discern the benefits and risks of the technological process. Looking at all angles, their article gives a wholistic approach to better appreciate the complexities of gene drive for biodefense. “Without a clear and detailed understanding of the range of social and technical factors that cause scientists to succeed or fail in their gene-drive endeavors, threat estimates can only rely on speculation and fantasy rather than fact.”
GMU Biodefense Students – Win Registration for 2017 ASM Biothreats Conference!
Calling all GMU Biodefense students – the program will be offering free registration to four lucky students to attend this premier biodefense event at the Marriott Wardman Park in Washington, DC on February 6-8th. This year, the meeting incorporates three major tracks, “Research, Response, and Policy” to cover relevant topics in basic and applied research; public health, emergency response and preparedness; and biosecurity, government, and policy responses. The exchange between these multidisciplinary communities will shape the future of this very important field. The keynote session on February 6 will be given by Thomas M. Countryman, Acting Under Secretary for Arms Control and International Security and Assistant Secretary to the Bureau of International Security and Nonproliferation at the Department of State. Anthony S. Fauci, M.D., Director of NIAID Director at the National Institutes of Health, will be presenting at a special session on February 7. You can find the rest of the agenda here. As an attendant for the 2016 conference, I can tell you that it’s a great experience for not only learning, but also networking. Please check your GMU email for the information Dr. Koblentz sent out. To apply: students are required to submit a 250-word essay about how attending the conference will benefit your education/professional aspirations by 5pm today (Friday, January 6th) to Dr. Koblentz. Winners will be announced the following Monday and those selected will be asked to write up summaries of at least two panels for publication in the Pandora Report.
USGS Disease Maps
 Love maps and diseases? Or do you simply like knowing what kinds of vectored diseases are transmitted around you? Check out the USGS disease maps that also allow you to interact with them. Utilizing data from CDC’s ArboNET, you can look at transmission among humans, mosquitoes, birds, sentinel animals, and veterinary transmission. The observable diseases include West Nile Virus, St. Louis Encephalitis, Eastern Equine Encephalitis, Western Equine Encephalitis, La Crosse Encephalitis, Powassan Virus, Dengue fever (locally acquired and imported), and Chikungunya (locally acquired and imported). The USGS disease maps allow us to not only have a better understanding of vectored disease transmission, but also landscape epidemiology.
Love maps and diseases? Or do you simply like knowing what kinds of vectored diseases are transmitted around you? Check out the USGS disease maps that also allow you to interact with them. Utilizing data from CDC’s ArboNET, you can look at transmission among humans, mosquitoes, birds, sentinel animals, and veterinary transmission. The observable diseases include West Nile Virus, St. Louis Encephalitis, Eastern Equine Encephalitis, Western Equine Encephalitis, La Crosse Encephalitis, Powassan Virus, Dengue fever (locally acquired and imported), and Chikungunya (locally acquired and imported). The USGS disease maps allow us to not only have a better understanding of vectored disease transmission, but also landscape epidemiology.
CRISPR Off-Switch
CRISPR is going to be a hot story in 2017 and here are the seven things to look for. The burgeoning concerns regarding CRISPR technology involve the rapid pace of development and lagging DURC policies, not to mention the inability to predict future outcomes. The interest and unease over this new form of genome editing has left many searching for an “off button”, but thankfully, researchers are believed to have found one. While the new “off switch” isn’t capable of reversing changes that were already made, it can stop the system from making additional edits. “The switch is a series of ‘anti-CRISPR’ proteins that were discovered inside viruses that attack bacteria, where they’re used to disable the gene editing tool and sneak into the bacterial DNA. ‘Just as CRISPR technology was developed from the natural anti-viral defence systems in bacteria, we can also take advantage of the anti-CRISPR proteins that viruses have sculpted to get around those bacterial defences,’ said lead researcher Benjamin Rauch. The team isolated these anti-CRISPR proteins from Listeria bacteria that had been infected by viruses. The team isolated the proteins that appeared to be involved and tested whether any of them could stop CRISPR editing from taking place in human cells. They found that two of these proteins, AcrIIA2 and AcrIIA4, worked together to inhibit the CRISPR systems commonly used by scientists.”
CDC Concludes CDP Ricin Exposure Inspection
The CDC just finished their inspection of the lab that sold the ricin toxin that was used by the Centers for Domestic Preparedness (CDP) training facility. The ongoing debate between the CDP and lab regarding the mishandling or misunderstanding points to bigger, systemic issues in regards to select agents. CDP states that the lab is to blame, noting that they ordered a less toxic version of ricin, while the lab rebutted by pointing out that the ricin was always properly labeled as the toxic version and they, in fact, never offered the less toxic version. The site visit and inspection findings are under review as the CDC determines if the lab is responsible and violated federal regulations. The conclusion of the inspection also comes at a challenging time for the CDC as the agency is taking heat for blacking out many details in reports recently released via the Freedom of Information Act. The released laboratory reports were requested by USA TODAY and only fuel the attention to lab incidents and poor biosafety practices.
NAS DURC Committee Meeting
This week the National Academies held the Committee on Dual Use Research of Concern (DURC): Option For Future Management. You can get not only the webcast recording (check out 2:42:00 in and you’ll see GMU Biodefense director and professor, Gregory Koblentz, talk about the zero sum game in terms of regulating DURC research – to regulate or not to regulate, that is the question!), but also the full presentations. Since the 2011 H5N1 controversies, “it remains unclear as to whether there are practical mechanisms or approaches for managing such dual use research of concern (DURC) and, specifically, how to deal with situations where there is a pressing need, for public health reasons, to publish research findings while limiting, due to national security concerns, the dissemination of certain details that ordinarily would be published. This is especially true in cases where an initial assessment of proposed research does not anticipate results that would warrant such consideration.”
Zika Outbreak Updates
Scientists are currently unveiling the key proteins in the virus that made it so deadly. The first comprehensive description of the Zika genome has identified seven key proteins that are helping researchers understand the devastation the virus does to the human body. “To test the virus, Dr. Zhao used fission yeast, a species that in recent years has become a relatively common way to test how pathogens affect cells. Fission yeast was originally used to make beer, particularly in Africa, where it originated. (Its species name is Schizosaccharomyces pombe; pombe means beer in Swahili.) Over decades, fission yeast has been used by many scientists to find out mechanisms and behavior of cells. For the experiment, Dr. Zhao and his colleagues separated each of the virus’s 14 proteins and small peptides from the overall virus. He then exposed yeast cells to each of the 14 proteins, to see how the cells responded. Seven of the 14 proteins harmed or damaged the yeast cells in some way, inhibiting their growth, damaging them or killing them.” The Entomological Society of America has noted that socioeconomic factors provide protection against a large scale Zika outbreak in the U.S., but that small outbreaks are an ongoing concern. As of January 4th, the CDC reported 4,618 cases of Zika in the U.S., of which 216 were locally-acquired.
Does the CDC’s New Quarantine Rule Violate Civil Liberties?
With a new vaccine and hopeful approach to emerging infectious diseases, have we buried Ebola? Back in August, the CDC proposed a new rule regarding its powers to respond to potential outbreaks via screening, testing, and quarantining people traveling into or within the U.S. You can read the new rule here, but it focuses on “non-invasive public health prevention measures” and reporting requirements for commercial passenger flights of death or illness to CDC, etc. While this may seem pretty reasonable given health emergencies like Ebola and SARS, many ” epidemiologists, lawyers, and health organizations say that the rule, in its current form poses a serious threat to civil liberties, allowing authorities to detain and examine people with little heed to due process and informed consent.” Attempted in 2005, this rule was initially met with criticism, however the recent Ebola outbreak has changed the way we approach travel during times of infectious disease outbreaks. Public health emergencies are defined as ‘communicable disease events’ that the director believes could be high risk for death or serious illness. “It is already authorized to detain people suspected of carrying diseases like plague, Ebola, and (somewhat improbably) smallpox. But the new rule does away with a formal list. It extends the same powers to any “quarantinable communicable disease,” and uses wider range of symptoms (from a list that federal agents can update as the need arises) for defining ‘ill’ people.” While the CDC can detain travelers prior to decision to quarantine, it notes that this shouldn’t last longer than 72 hours and fails to make provisions for a lawyer if the person can’t afford one. “The rule also gives the CDC ultimate authority to carry out medical tests and treatments, stating that ‘the individual’s consent shall not be considered as a prerequisite to the exercise of any authority’.” What are your thoughts? We’d love to hear from our readership – please email or tweet @PandoraReport to give us your thoughts!
USDA ARS 4th International Biosafety & Biocontainment Symposium Registration Deadline
Don’t miss the January 13th registration deadline for this event in Baltimore, Maryland! From February 6-9, the focus of the symposium will be Global Biorisk Challenges-Agriculture and Beyond. Seven presymposium courses will address topics including unique biocontainment challenges, decontamination and inactivation, and institutional governance. Topics include biorisk management challenges in a One Health World, arthropods, HPAI, risk assessments, and more!
Stories You May Have Missed:
- 85 People Suspected to Have Contracted Rabies– Like something out of a zombie movie, 85 people are suspected of having contracted wild rabies after being bitten by bats in Peru. “Regional director of Health of Cusco, Julio César Espinosa La Torre said that among the group of victims with a bat bite are the 15 soldiers transferred to Lima, of this group, two cases were confirmed, of which one is deceased. Espinoza la Torre said that to date, more than 912 civilians and 680 soldiers have been vaccinated in Alto and Bajo Urubamba, in the district of Megantoni, who must receive up to four doses, every 7 and 14 days.”
- Anticipating Epidemics Using Computational Models – the White House recently released a report to strengthen the capacity for outbreak prediction. Spearheaded by the National Science and Technology Council, Toward Epidemic Prediction: Federal Efforts and Opportunities in Outbreak Modeling, looks to predictive modeling and data utilization to better understand the “processes that drive disease emergence and transmission could help to predict and prevent large-scale outbreaks. These programs range from foundational research into disease emergence and spillover, to predictive modeling contests, to the development of decision-support technologies for public health responders.”
- Pandemic Chats – Struggling to chat to a younger generation about diseases? Check out how the Bill & Melinda Gates Foundation is talking to the next generation about the next pandemic.